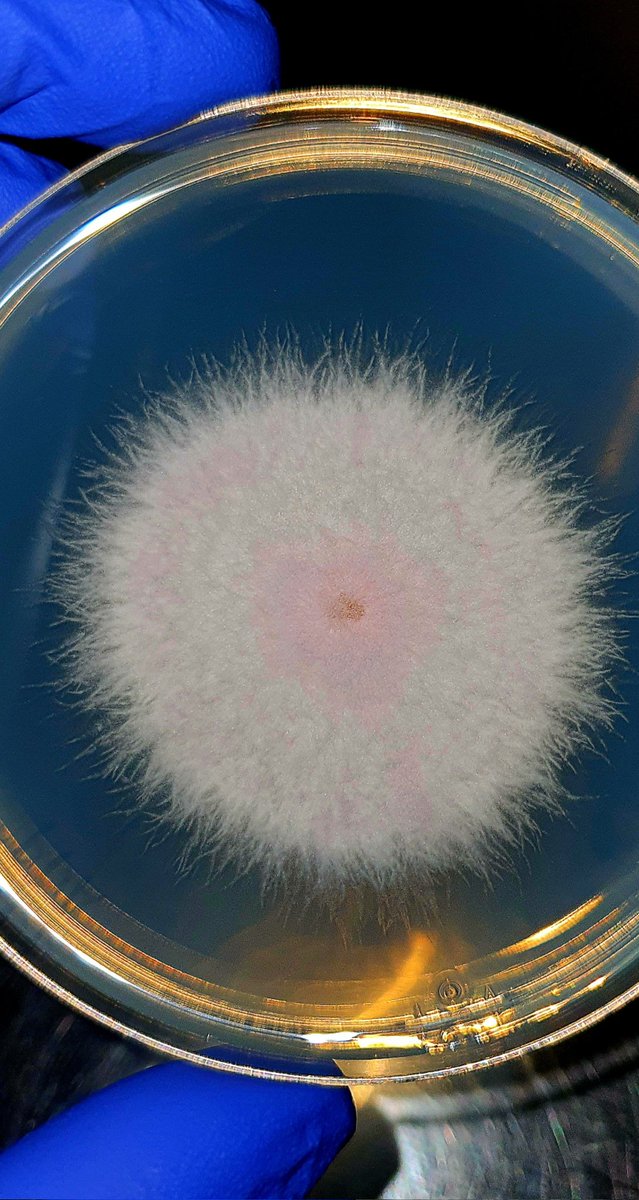
Aamer Kurdi tweet media

Sabitlenmiş Tweet
NA
666 posts


رابط تقديم تعاقد مؤقت ( لوكم ) مع مستشفى د.سليمان الحبيب للعمل بموسم الحج 1447 هـ بمكه المكرمه
app.smartsheet.com/b/form/019d876…
#حج_1447هـ #لوكم

العربية
NA retweetledi
NA retweetledi
NA retweetledi
NA retweetledi
NA retweetledi
NA retweetledi